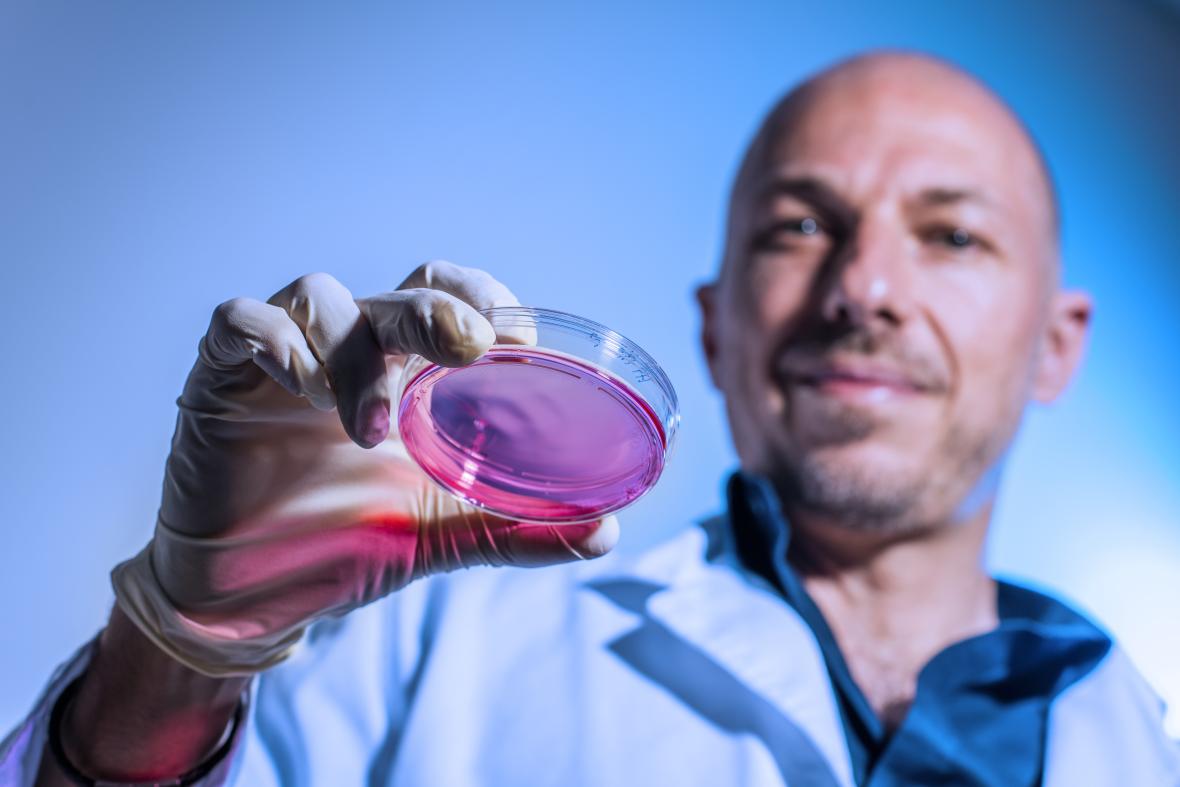
Person wearing gloves holding a clear petri dish containing pink contents.

We're midway through spring and the renewed sense of energy can be felt all around, including in digital health. In this issue we cover all the new innovations and updates happening in this space, including the latest news about pathology reports, updates about the new virtual events for Fast Healthcare Interoperability Resources® (FHIR®), and more.
We're also sharing our latest collab with Guardian Australia, highlighting a few cyber security tips from the Australian Department of Home Affairs, and showcasing some of the latest innovations from around the globe.
Subscribe to Inside Digital Health on LinkedIn
Immediate access to most pathology reports empowers Australians and their care teams
The latest media release from the Australian Digital Health Agency notes that access to timely and accurate pathology reports is a critical challenge for healthcare teams. Australians living with chronic or complex conditions often rely on care from a range of professionals like specialists, GPs, nurses and allied health practitioners, who all need up-to-date information to coordinate and optimise care, even if they are not the original requester of the test. Delays in receiving pathology results can slow decision-making, impact communication between providers and affect outcomes for healthcare consumers.
Recognising these issues, the Agency has now enabled faster access to pathology reports through My Health Record and the my health app. This ensures Australians and all members of their healthcare team can promptly view and act on important health information.
Agency CEO Amanda Cattermole PSM said this improvement is designed to streamline collaboration, facilitate earlier discussions and enhance the overall quality of care delivered.
“Putting timely health information in the hands of Australians and their care teams through My Health Record and my health app supports safer, more connected care. These access changes to most pathology reports, empowers both consumers and healthcare professionals to act quickly, make informed decisions, and ultimately improve health outcomes”
- Agency CEO Amanda Cattermole PSM
📰 Read the full media release.
💻 What it means for consumers: Better and Faster Access
⚕️ What its means for healthcare providers: Better and Faster Access to health information
FHIRside weekly sessions
If you're learning about or working with Fast Healthcare Interoperability Resources® (FHIR®) standards and looking for a space to connect, ask questions, and share ideas in real time, then join us at the FHIRside.
This new weekly series of informal virtual drop-in sessions, is for anyone working with or learning about FHIR® standards.
Hosted by the Agency in partnership with HL7 Australia, the FHIRside series of informal virtual drop-in sessions is designed for those learning about or working with FHIR. The sessions are open to developers, implementers and enthusiasts across government, jurisdictions, industry and the broader health sector community.
Whether you're new to FHIR or a seasoned implementer, FHIRside is your opportunity to connect, ask, and make progress toward the future of interoperability in Australia through:
- real-time access to FHIR experts
- peer-to-peer learning and support
- a safe, inclusive space to ask questions
- cross-agency collaboration
- community-led innovation
FHIRside complements existing platforms, development activities and formal training programs by offering a welcoming space for informal discussion, idea testing and knowledge sharing.
🔥 To join us around the FHIRside – head to our website every Tuesday from 12:30 to 13:30 (AEDT) or subscribe to our LinkedIn channel for future updates.

In an ongoing collab with Guardian Australia, we're sharing compelling stories of real Australian families and the positive impact My Health Record and my health app are having on their lives.

For Adelaide mother and healthcare educator Allyson Hickey, being able to easily access her own health records in a way that works for her has been nothing short of life-changing.
Born with Stickler Syndrome - a rare genetic condition that affects hearing, vision and joints – Allyson lives with a sight impairment and moderate hearing loss that affects every aspect of her daily life.
While she has learned strategies to adapt and manage on a day-to-day basis, Allyson relies on support workers, assistive technology and the help of her husband to juggle the demands of life. She also relies on my health app to manage her and her family’s health needs.
“For a person with disabilities, I find my health app especially easy and accessible to use,” she says. “The interface is easily readable and the whole app is very accessible, particularly for someone with a vision impairment.”
To make reading easier, Allyson uses the accessibility feature in the my health app to check:
🩸 blood test results,
📝 referrals
⌚ appointment notes
“I use dark mode and I increase the text size. I also really appreciate the colour coding. It’s quite user friendly and very readable.”
📱 More information about my health app can be found on our website.
It's Cyber Awareness Month. Take 5 minutes to check that your cyber security is up to scratch.
October is Cyber Awareness Month and this year's theme is 'Building our cyber security'. If you have 5 minutes, take the new cyber health check. This free tool helps you do a basic cyber security assessment. It's great for individuals, small businesses and not-for-profits who want to improve their cyber security but aren’t sure what to do. And once you've completed the check, you'll have personalised advice to improve your cyber security.
🕵️ Are you a healthcare provider who would like to become a cyber champion?
Join the Digital Health Cyber Champions Network and get practical tips to stay ahead of cyber threats and help safeguard your workplace.

Low-cost tool could one day detect leukemia in a patient’s saliva

Imagine being able to test for leukemia with just a bit of spit - no needles, no hospital visits. That’s exactly what Dr Dan Yuan and her team at The University of Queensland are working on. They’re developing a low-cost, saliva-based diagnostic tool that could one day make disease detection as easy as brushing your teeth.
Dr Yuan’s research dives into viscoelastic microfluidics (basically, how tiny particles move through fluid), and it’s helping her design a device that can spot abnormal cells in saliva. Think COVID test kits, but for cancer screening.
Read the full article at the University of Queensland website.
Researchers say they've taken another step towards curing blindness
A research team at Bond University is testing a therapy for blindness in pigs, aiming to find a cure for age-related macular degeneration and retinitis pigmentosa in humans.
Dr Jason Limnios leads the Stem Cell Research Group at the Clem Jones Centre for Regenerative Medicine (CJCRM) at Bond and has developed core stem cell technologies for therapies.
Given that stem cell therapies are an emerging technology, there is a long road between lab breakthroughs and proving the treatment is effective in humans.
Read more about the work at the Bond University website.

Does your healthcare provider organisation need a simpler way to manage information?
The Agency's Provider Connect Australia™ (PCA™) can simplify provider management by sharing updated details to connected systems. Faster registration, fewer errors, less admin.
🖥️ Find out how to register on our website.

In direct response to feedback from stakeholders who have expressed a desire for more consistent and accessible updates from across the Agency, we are pleased to introduce Partnership Pulse.
The bi-monthly stakeholder newsletter will keep you regularly informed about Agency programs, events, consultations, and sector insights.
🗞️ Read the first edition on the Agency's website.
🗒️ Subscribe and have them sent directly to your inbox.

If you're looking for a role that's professionally and personally rewarding and offers career growth and mentoring, check out the latest jobs at the Australian Digital Health Agency.
- Temporary Employment Register – always open
- APS Section 26 Transfer - Permanent and Temporary - Employment Register – always open
See more vacancies on our careers page.
Email: social@digitalhealth.gov.au
Subscribe: To keep up to date with digital health news, events and more.
Follow: Like, follow and join the digital health conversation.

